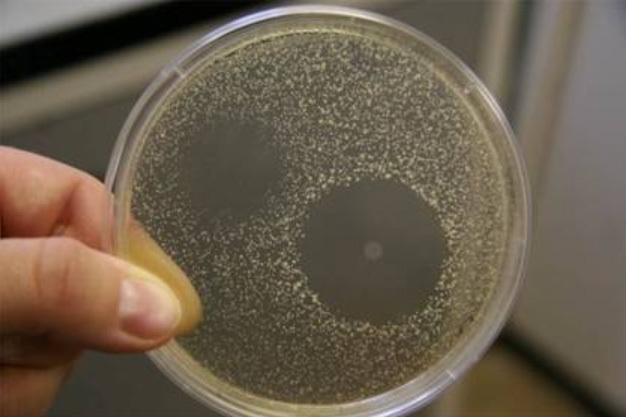

Observation 11: Hemingway once said that “If you are lucky enough to have lived in Paris as a young man, then wherever you go for the rest of your life, it stays with you, for Paris is a moveable feast.” Alison once said that “If you’re lucky enough to live in Paris when you’re getting up there in age, then take a Z-Pac, for Paris is a moveable Petri dish”. We have been sick off and on for weeks as has everyone in school and everyone on the subway and–sorry, Marsha, Barb and Laura– everyone who has visited us.
In spite of the fact that I believed myself to be dying of tuberculosis, (see Observation 11), Saturday we visited Chateau de Vincennes located on the far east end of Paris. At some point it was converted from castle to prison. It was eerie to see centuries old names carved on the walls by former prisoners.




We’ve been doing a lot of “reconnaissance shopping” this week with plans to return to our favorite places another time for buying.
1. BHV. It sells everything from a hardware store items to women’s lingerie with more affordable prices than the Galleries Lafayette.
6. Consignment store called Reciproque. It was actually located in about five different stores along rue de la Pompe. Very haute couture women’s clothing, shoes, purses, etc. Though the clothes are still a bit pricey the shoes, some of which likely retailed for more than a thousand dollars new, were priced from around $100-$400 and all were all in nearly new shape.
We’ve both lost weight since we’ve been here (see Observation 11) but Joan is getting really thin. Her pants fit her so big that when she tucks them into her boots she looks like a Germain WW11 soldier, which probably isn’t all that fashionable here. I think she’s going to have to buy new pants.







You are killing me with the shopping. Do you not love the basement at BHV? Also look for a chain called Le Vaissellerie – there are several. Green and white awnings, fun basic french house stuff. Oh, and I love the makeup counter at the Monoprix.
LikeLike
You guys sound like you are having fun. The weight loss in any woman’s eyes is just an added blessing. LOL Love you guys.
LikeLike
Every time we go to Paris, every year lately, and stay through November for part of the concert season I come home sick. I can count on it, just part of the experience, I guess. Or maybe just part of using the Metro.
LikeLike